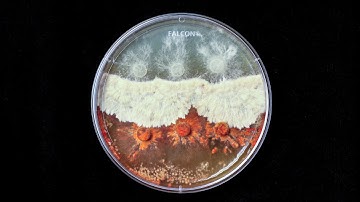
Fungi Fighting Timelapse

⬇ DOWNLOAD NOW
Kalau muncul iklan pop-up, tutup lalu klik tombol kembali
Download lagu Trichoderma Mold Fungi Timelapse secara gratis hanya untuk keperluan promosi. Dukung artis favorit kamu dengan membeli musik original di iTunes atau platform resmi lainnya.
Fungi Fighting Timelapse
Fungi Fighting Timelapse
 "Fantastic Fungi" time-lapses by Stephen Axford
"Fantastic Fungi" time-lapses by Stephen Axford
 Evolução de um fungo trichoderma/ time lapse
Evolução de um fungo trichoderma/ time lapse
 Mushroom Contamination - Bacillus (Wetspot) and Trichoderma (Green Mold)
Mushroom Contamination - Bacillus (Wetspot) and Trichoderma (Green Mold)
 Mold Time Lapse
Mold Time Lapse
 Trichoderma Viride Timelapse
Trichoderma Viride Timelapse
 Pleurotus mycelium vs Trichoderma (Timelapse)
Pleurotus mycelium vs Trichoderma (Timelapse)
 Fungi Timelapse Compilation 01
Fungi Timelapse Compilation 01